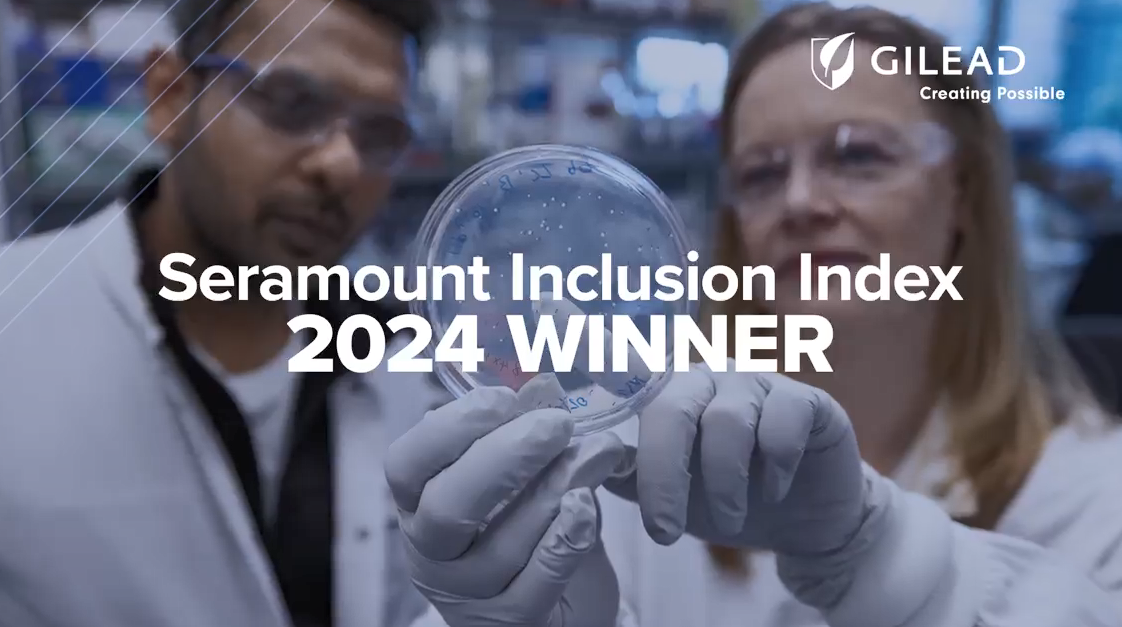
Two people looking at a petri dish that one is holding up. "Seramount Inclusion Index 2024 Winner".

Video
This year, we’re among 42 organizations being recognized by Seramount as a Leading Inclusion Index Company. The recognition highlights the connections we foster, the opportunities we create for underrepresented groups and the sense of belonging we cultivate.
Gilead Sciences
Gilead Sciences, Inc. is a research-based biopharmaceutical company that discovers, develops and commercializes innovative medicines in areas of unmet medical need. The company strives to transform and simplify care for people with life-threatening illnesses around the world. Gilead has operations in more than 35 countries worldwide, with headquarters in Foster City, California.
